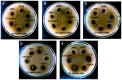

Synergistic Nanocomposites of Different Antibiotics Coupled with Green Synthesized Chitosan-Based Silver Nanoparticles: Characterization, Antibacterial, in vivo Toxicological and Biodistribution Studies
- PMID: 33116504
- PMCID: PMC7568684
- DOI: 10.2147/IJN.S274987
Synergistic Nanocomposites of Different Antibiotics Coupled with Green Synthesized Chitosan-Based Silver Nanoparticles: Characterization, Antibacterial, in vivo Toxicological and Biodistribution Studies
Retraction in
-
Synergistic Nanocomposites of Different Antibiotics Coupled with Green Synthesized Chitosan-Based Silver Nanoparticles: Characterization, Antibacterial, in vivo Toxicological and Biodistribution Studies [Retraction].Int J Nanomedicine. 2021 Dec 9;16:8035-8036. doi: 10.2147/IJN.S352905. eCollection 2021. Int J Nanomedicine. 2021. PMID: 34916793 Free PMC article.
Abstract
Purpose: The present study reports chitosan functionalized green synthesized CS-AgNPs, conjugated with amoxicillin (AMX), cefixime (CEF), and levofloxacin (LVX) for safe and enhanced antibacterial activity.
Methods: The CS-AgNPs and conjugates CS-AgNPs+AMX CS-AgNPs+CEF, and CS-AgNPs+LVX were characterized by UV-Vis, FTIR, SEM, TEM, EDX spectroscopy. The size distribution and zeta potential were measured using the dynamic light scattering (DLS) technique. The interaction between CS-AgNPs and antibiotic molecules was also investigated using UV-Vis spectroscopy at the concentrations of 5, 50, 500, and 5000 µM for each antibiotic. Antibacterial activity and synergism were assessed by the Fractional Inhibitory Concentration (FIC) index. The mechanism for synergistic activity was investigated by the detection of hydroxyl species based on the chemiluminescence of luminol. The biocompatibility index (BI) was calculated from IC50 using the HeLa cell line. In vivo toxicity and tissue distribution of silver ions were evaluated on Sprague Dawley rats. Physical interactions of antibiotics and significant (P<0.05) antibacterial activity were observed after loading on CS-AgNPs surfaces.
Results: The spherical shape nanocomposites of CS-AgNPs with different antibiotics were prepared with mean size ranges of 80-120 nm. IC50 of antibiotics-conjugated CS-AgNPs decreased compared to CS-AgNPs. The biocompatibility (BI) index showed that antibiotics-conjugated CS-AgNPs have high antibacterial potential and low toxicity. Highly significant (P<0.005) increase in the generation of hydroxyl species indicated the radical scavenging mechanism for synergistic activity of CS-AgNPs after combined with different antibiotics. Biochemical analysis and histopathological examinations confirmed low toxicity with minor hepatotoxicity at higher doses. After oral administration, extensive distribution of Ag ion was observed in spleen and liver.
Conclusion: The study demonstrates positive attributes of antibiotics-conjugated CS-AgNPs, as a promising antibacterial agent with low toxicity.
Keywords: antibiotic resistance; chitosan functionalized silver nanoparticles; in vivo toxicity; synergistic antibacterial activity; tissue distribution.
© 2020 Asghar et al.
Conflict of interest statement
The authors report no conflicts of interest in this work.
Figures

References
-
- Kumari RM, Goswami R, Nimesh S. Application of nanotechnology in diagnosis and therapeutics. Nanotechnol Energy Environ Eng. 2020;413–440.
-
- Asghar MA, Zahir E, Asghar MA, Iqbal J, Rehman AA. Facile, one-pot biosynthesis and characterization of iron, copper and silver nanoparticles using Syzygium cumini leaf extract: as an effective antimicrobial and aflatoxin B1 adsorption agents. PLoS One. 2020;15(7):p.e0234964. doi: 10.1371/journal.pone.0234964 - DOI - PMC - PubMed
-
- Alavi M, Naser K, Tahereh V. Antibacterial, antibiofilm, antiquorum sensing, antimotility, and antioxidant activities of green fabricated Ag, Cu, TiO2, ZnO, and Fe3O4 NPs via protoparmeliopsis muralis lichen aqueous extract against multi-drug-resistant bacteria. ACS Biomat Sci Eng. 2019;5:4228–4243. doi: 10.1021/acsbiomaterials.9b00274 - DOI - PubMed
Publication types
MeSH terms
Substances
LinkOut - more resources
Full Text Sources
Medical

